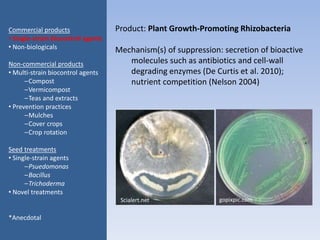
Product: Plant Growth-Promoting Rhizobacteria
Mechanism(s) of suppression: secretion of bioactive
molecules such as antibiotics and cell-wall
degrading enzymes (De Curtis et al. 2010);
nutrient competition (Nelson 2004)
Commercial products
• Single-strain biocontrol agents
• Non-biologicals
Non-commercial products
• Multi-strain biocontrol agents
–Compost
–Vermicompost
–Teas and extracts
• Prevention practices
–Mulches
–Cover crops
–Crop rotation
Seed treatments
• Single-strain agents
–Psuedomonas
–Bacillus
–Trichoderma
• Novel treatments
*Anecdotal
Scialert.net gopixpic.com

This document discusses biological control for plant disease management. It begins with introducing biological control products and their effectiveness, noting that understanding options and effectiveness is key to disease management. It then reviews factors that influence the effectiveness of biological control, finding that disease pressure, aerial vs soilborne diseases, and annual vs perennial crops do not significantly impact efficacy. Fungal and bacterial biocontrol agents and pathogens also show no difference in efficacy. The document dives deeper into analyzing specific products like Trichoderma spp., their active ingredients, uses, mechanisms of suppression, and evaluations. It finds products like RootShield with T. harzianum generally work well but may be affected by dry conditions and lack registration.